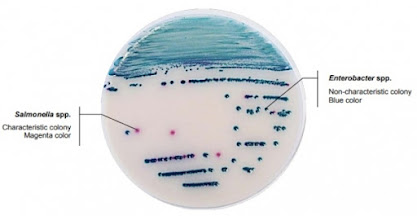

ISO 21527-1 tam karşılayan DRBC agar BİLİYOR MUYDUNUZ? Dichloran Rose Bengal Chloramphenicol (DRBC) Agar toz besiyeri muhteviyatında bulunan 4 bileşen ile çok daha seçici ve ayırt edicidir. Bileşiminde bulunan Çinko ve Bakır Sülfat küflerin pigment üretimini geliştirir, Klortetrasiklin ise besiyerinin bakteriyel kirleticilerin önemli bir kısmına karşı seçiciliğini pekiştirir, Tergitol ise Mucor proliferasyonunu sınırlandırır. Ayrıca Biokar DRBC agar bileşimi ISO 21527-1 standardında tanımlanmış tipik kompozisyonu karşılar. Siparişiniz için: BK198HA DRBC agar - 500g BM14208 DRBC agar - 10x200mL